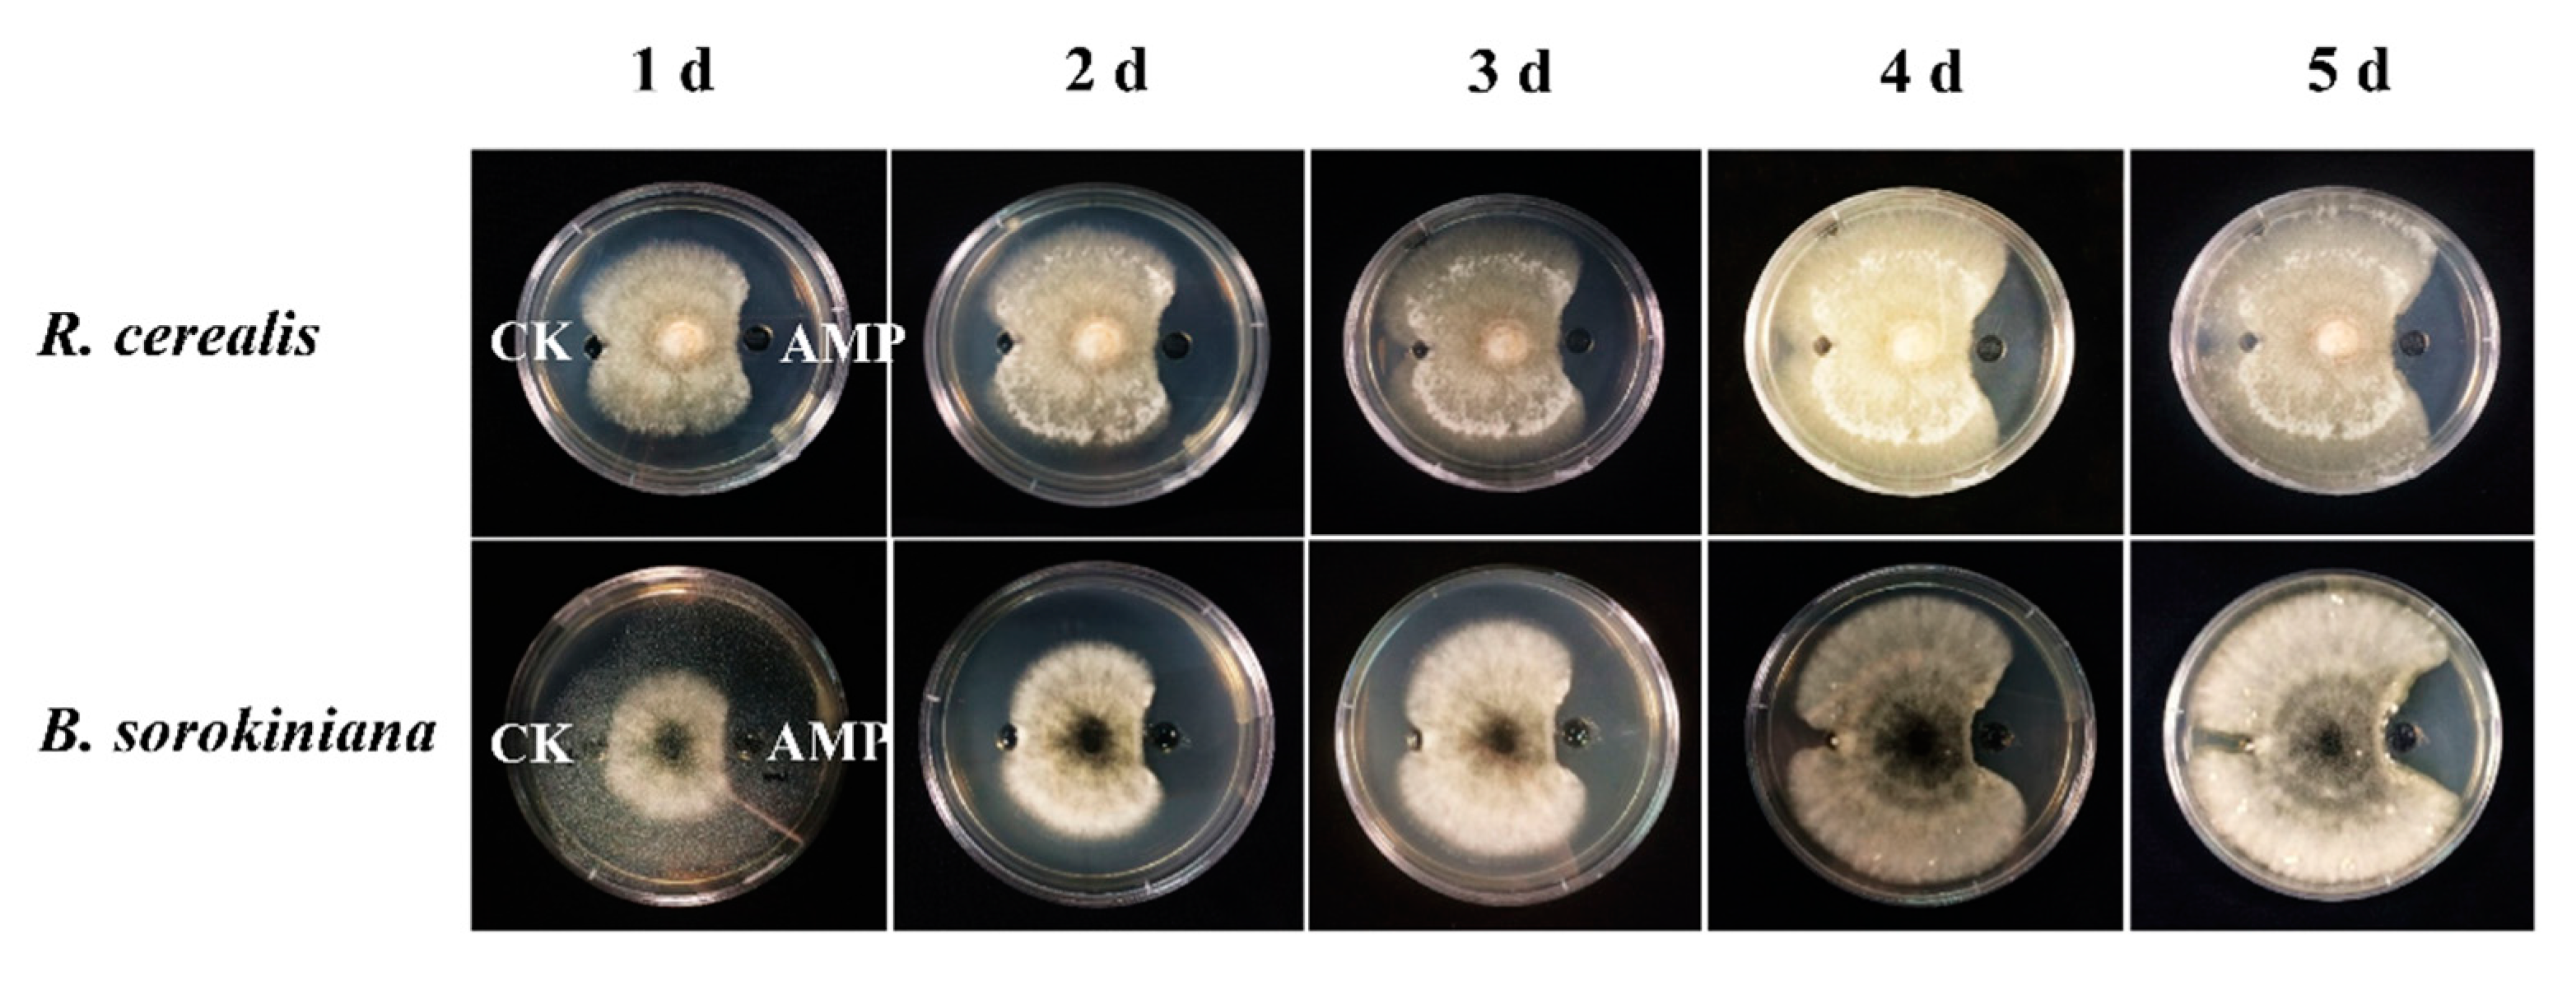
Ijms 21 00647 g002 Ijms 21 00647 g002

Ecotopic Expression of the Antimicrobial Peptide DmAMP1W Improves Resistance of Transgenic Wheat to Two Diseases: Sharp Eyespot and Common Root Rot
Abstract
1. Introduction
2. Results
2.1. Heterogonous Expression and Purification of DmAMP1W
2.2. DmAMP1W In Vitro Inhibits Growth of R. cerealis and B. sorokiniana
2.3. Generation and Molecular Characterization of DmAMP1W Transgenic Wheat
2.4. DmAMP1W Expression Improves Resistance of Transgenic Wheat to Sharp Eyespot and Common Root Rot
3. Discussion
4. Materials and Methods
4.1. Plant Materials and Pathogenic Fungi
4.2. Construction of pMAL-C5X-DmAMP1W Prokaryotic Expression Vector
4.3. Induction, Extraction and Purification of MBP-DmAMP1W Fusion Proteins
4.4. MBP-DmAMP1W Antifungal Activity Assay In Vitro
4.5. Generation of DmAMP1W Transgenic Wheat Plants
4.6. DNA and RNA Extractions and cDNA Synthesis of Wheat
4.7. PCR and RT-(q)PCR Analyses of DmAMP1W Transgene in Wheat
4.8. Western Blot Analysis on DmAMP1W Transgene Wheat
4.9. Wheat Sharp Eyespot and Common Root Rot Assessments
Supplementary Materials
Author Contributions
Funding
Acknowledgments
Conflicts of Interest
Abbreviations
| AA | amino acid |
| AMP | antimicrobial peptide |
| DI | disease index |
| IPTG | isopropyl-β-D-thiogalactopyranoside |
| IT | infection type |
| MBP | maltose binding protein |
| RT-qPCR | reverse-transcription quantitative polymerase chain reaction |
| PBS | phosphate buffer saline |
References
- Scofield, S.R.; Huang, L.; Brandt, A.S.; Gill, B.S. Development of a virus-induced gene-silencing system for hexaploid wheat and its use in functional analysis of the Lr21-mediated leaf rust resistance pathway. Plant Physiol. 2005, 138, 2165–2173. [Google Scholar] [CrossRef] [PubMed]
- Hamada, M.S.; Yin, Y.; Chen, H.; Ma, Z. The escalating threat of Rhizoctonia cerealis, the causal agent of sharp eyespot in wheat. Pest Manag. Sci. 2011, 67, 1411–1419. [Google Scholar] [CrossRef] [PubMed]
- Chen, L.; Zhang, Z.; Liang, H.; Liu, H.; Du, L.; Xu, H.; Xin, Z. Overexpression of TiERF1 enhances resistance to sharp eyespot in transgenic wheat. J. Exp. Bot. 2008, 59, 4195–4204. [Google Scholar] [CrossRef] [PubMed]
- Zhu, X.; Lu, C.; Du, L.; Ye, X.; Liu, X.; Coules, A.; Zhang, Z. The wheat NB-LRR gene TaRCR1 is required for host defence response to the necrotrophic fungal pathogen Rhizoctonia cerealis. Plant Biotechnol. J. 2017, 15, 674–687. [Google Scholar] [CrossRef] [PubMed]
- Lemańczyk, G.; Kwaśna, H. Effects of sharp eyespot (Rhizoctonia cerealis) on yield and grain quality of winter wheat. Eur. J. Plant Pathol. 2013, 135, 187–200. [Google Scholar] [CrossRef]
- Wang, M.; Zhu, X.; Wang, K.; Lu, C.; Luo, M.; Shan, T.; Zhang, Z. A wheat caffeic acid 3-O-methyltransferase TaCOMT-3D positively contributes to both resistance to sharp eyespot disease and stem mechanical strength. Sci. Rep. 2018, 8, 6543. [Google Scholar] [CrossRef]
- Wei, X.; Shan, T.; Hong, Y.; Xu, H.; Liu, X.; Zhang, Z. TaPIMP2, a pathogen-induced MYB protein in wheat, contributes to host resistance to common root rot caused by Bipolaris sorokiniana. Sci. Rep. 2017, 7, 1754. [Google Scholar] [CrossRef]
- Kumar, J.; Schafer, P.; Huckelhoven, R.; Langen, G.; Baltruschat, H.; Stein, E.; Nagarajan, S.; Kogel, K.H. Bipolaris sorokiniana, a cereal pathogen of global concern: Cytological and molecular approaches towards better control double dagger. Mol. Plant Pathol. 2002, 3, 185–195. [Google Scholar] [CrossRef]
- Kumar, U.; Joshi, A.K.; Kumar, S.; Chand, R.; Roder, M.S. Mapping of resistance to spot blotch disease caused by Bipolaris sorokiniana in spring wheat. Theor. Appl. Genet. 2009, 118, 783–792. [Google Scholar] [CrossRef]
- Nawrot, R.; Barylski, J.; Nowicki, G.; Broniarczyk, J.; Buchwald, W.; Gozdzicka-Jozefiak, A. Plant antimicrobial peptides. Folia Microbiol. 2014, 59, 181–196. [Google Scholar] [CrossRef]
- Yount, N.Y.; Yeaman, M.R. Peptide antimicrobials: Cell wall as a bacterial target. Ann. N. Y. Acad. Sci. 2013, 1277, 127–138. [Google Scholar] [CrossRef] [PubMed]
- Parisi, K.; Shafee, T.; Quimbar, P.; van der Weerden, N.L.; Bleackley, M.R.; Anderson, M.A. The evolution, function and mechanisms of action for plant defensins. Semin. Cell Dev. Biol. 2019, 88, 107–118. [Google Scholar] [CrossRef] [PubMed]
- Jha, S.; Chattoo, B.B. Expression of a plant defensin in rice confers resistance to fungal phytopathogens. Transgenic Res. 2010, 19, 373–384. [Google Scholar] [CrossRef] [PubMed]
- Osborn, R.W.; De Samblanx, G.W.; Thevissen, K.; Goderis, I.; Torrekens, S.; Van Leuven, F.; Attenborough, S.; Rees, S.B.; Broekaert, W.F. Isolation and characterisation of plant defensins from seeds of Asteraceae, Fabaceae, Hippocastanaceae and Saxifragaceae. FEBS Lett. 1995, 368, 257–262. [Google Scholar] [CrossRef]
- Tang, S.S.; Prodhan, Z.H.; Biswas, S.K.; Le, C.F.; Sekaran, S.D. Antimicrobial peptides from different plant sources: Isolation, characterisation, and purification. Phytochemistry 2018, 154, 94–105. [Google Scholar] [CrossRef]
- Thevissen, K.; Terras, F.R.; Broekaert, W.F. Permeabilization of fungal membranes by plant defensins inhibits fungal growth. Appl. Environ. Microbiol. 1999, 65, 5451–5458. [Google Scholar] [CrossRef]
- Thevissen, K.; Osborn, R.W.; Acland, D.P.; Broekaert, W.F. Specific binding sites for an antifungal plant defensin from Dahlia (Dahlia merckii) on fungal cells are required for antifungal activity. Mol. Plant Microbe Interact. 2000, 13, 54–61. [Google Scholar] [CrossRef]
- Lacerda, A.F.; Vasconcelos, E.A.; Pelegrini, P.B.; Grossi, D.S.M. Antifungal defensins and their role in plant defense. Front. Microbiol. 2014, 5, 116. [Google Scholar] [CrossRef]
- De Lucca, A.J.; Jacks, T.J.; Broekaert, W.J. Fungicidal and binding properties of three plant peptides. Mycopathologia 1998, 144, 87–91. [Google Scholar] [CrossRef]
- Li, Z.; Zhou, M.; Zhang, Z.; Ren, L.; Du, L.; Zhang, B.; Xu, H.; Xin, Z. Expression of a radish defensin in transgenic wheat confers increased resistance to Fusarium graminearum and Rhizoctonia cerealis. Funct. Integr. Genom. 2011, 11, 63–70. [Google Scholar] [CrossRef]
- Sher, K.R.; Iqbal, A.; Malak, R.; Shehryar, K.; Attia, S.; Ahmed, T.; Ali, K.M.; Arif, M.; Mii, M. Plant defensins: Types, mechanism of action and prospects of genetic engineering for enhanced disease resistance in plants. 3 Biotech 2019, 9, 192. [Google Scholar] [CrossRef] [PubMed]
- Terras, F.; Schoofs, H.; Thevissen, K.; Osborn, R.W.; Vanderleyden, J.; Cammue, B.; Broekaert, W.F. Synergistic enhancement of the antifungal activity of wheat and barley thionins by radish and oilseed rape 2S albumins and by barley trypsin inhibitors. Plant Physiol. 1993, 103, 1311–1319. [Google Scholar] [CrossRef] [PubMed]
- Almeida, M.S.; Cabral, K.S.; de Medeiros, L.N.; Valente, A.P.; Almeida, F.C.; Kurtenbach, E. cDNA cloning and heterologous expression of functional cysteine-rich antifungal protein Psd1 in the yeast Pichia pastoris. Arch. Biochem. Biophys. 2001, 395, 199–207. [Google Scholar] [CrossRef] [PubMed]
- Spelbrink, R.G.; Dilmac, N.; Allen, A.; Smith, T.J.; Shah, D.M.; Hockerman, G.H. Differential antifungal and calcium channel-blocking activity among structurally related plant defensins. Plant Physiol. 2004, 135, 2055–2067. [Google Scholar] [CrossRef] [PubMed]
- Zhu, Y.J.; Agbayani, R.; Moore, P.H. Ectopic expression of Dahlia merckii defensin DmAMP1 improves papaya resistance to Phytophthora palmivora by reducing pathogen vigor. Planta 2007, 226, 87–97. [Google Scholar] [CrossRef] [PubMed]
- Jha, S.; Tank, H.G.; Prasad, B.D.; Chattoo, B.B. Expression of Dm-AMP1 in rice confers resistance to Magnaporthe oryzae and Rhizoctonia solani. Transgenic Res. 2009, 18, 59–69. [Google Scholar] [CrossRef] [PubMed]
- Thevissen, K.; Francois, I.E.; Takemoto, J.Y.; Ferket, K.K.; Meert, E.M.; Cammue, B.P. DmAMP1, an antifungal plant defensin from dahlia (Dahlia merckii), interacts with sphingolipids from Saccharomyces cerevisiae. FEMS Microbiol. Lett. 2003, 226, 169–173. [Google Scholar] [CrossRef]
- Im, Y.J.; Idkowiak-Baldys, J.; Thevissen, K.; Cammue, B.P.; Takemoto, J.Y. IPT1-independent sphingolipid biosynthesis and yeast inhibition by syringomycin E and plant defensin DmAMP1. FEMS Microbiol. Lett. 2003, 223, 199–203. [Google Scholar] [CrossRef]
- Montesinos, E.; Bardaji, E. Synthetic antimicrobial peptides as agricultural pesticides for plant-disease control. Chem. Biodivers. 2008, 5, 1225–1237. [Google Scholar] [CrossRef]
- Rajasekaran, K.; Cary, J.W.; Jaynes, J.M.; Cleveland, T.E. Disease resistance conferred by the expression of a gene encoding a synthetic peptide in transgenic cotton (Gossypium hirsutum L.) plants. Plant Biotechnol. J. 2005, 3, 545–554. [Google Scholar] [CrossRef]
- Gaspar, Y.M.; McKenna, J.A.; McGinness, B.S.; Hinch, J.; Poon, S.; Connelly, A.A.; Anderson, M.A.; Heath, R.L. Field resistance to Fusarium oxysporum and Verticillium dahliae in transgenic cotton expressing the plant defensin NaD1. J. Exp. Bot. 2014, 65, 1541–1550. [Google Scholar] [CrossRef] [PubMed]
- Patkar, R.N.; Chattoo, B.B. Transgenic Indica rice expressing ns-LTP-Like protein shows enhanced resistance to both fungal and bacterial pathogens. Mol. Breed. 2006, 17, 159–171. [Google Scholar] [CrossRef]
- Roy-Barman, S.; Sautter, C.; Chattoo, B.B. Expression of the lipid transfer protein Ace-AMP1 in transgenic wheat enhances antifungal activity and defense responses. Transgenic Res. 2006, 15, 435–446. [Google Scholar] [CrossRef] [PubMed]
- Thevissen, K.; Cammue, B.P.; Lemaire, K.; Winderickx, J.; Dickson, R.C.; Lester, R.L.; Ferket, K.K.; Van Even, F.; Parret, A.H.; Broekaert, W.F. A gene encoding a sphingolipid biosynthesis enzyme determines the sensitivity of Saccharomyces cerevisiae to an antifungal plant defensin from dahlia (Dahlia merckii). Proc. Natl. Acad. Sci. USA 2000, 97, 9531–9536. [Google Scholar] [CrossRef] [PubMed]
- Yang, K.; Liu, X.; Du, L.P.; Ye, X.G.; Zhang, Z.Y. Development and characterization of AcAMP-sn transgenic wheat with enhanced resistance to wheat take-all. Acta Agron. Sin. 2014, 40, 22. (In Chinese) [Google Scholar] [CrossRef]
- Almasia, N.I.; Bazzini, A.A.; Hopp, H.E.; Vazquez-Rovere, C. Overexpression of snakin-1 gene enhances resistance to Rhizoctonia solani and Erwinia carotovora in transgenic potato plants. Mol. Plant Pathol. 2008, 9, 329–338. [Google Scholar] [CrossRef]
- Rong, W.; Qi, L.; Wang, J.; Du, L.; Xu, H.; Wang, A.; Zhang, Z. Expression of a potato antimicrobial peptide SN1 increases resistance to take-all pathogen Gaeumannomyces graminis var. tritici in transgenic wheat. Funct. Integr. Genom. 2013, 13, 403–409. [Google Scholar] [CrossRef]
- Breen, S.; Solomon, P.S.; Bedon, F.; Vincent, D. Surveying the potential of secreted antimicrobial peptides to enhance plant disease resistance. Front. Plant Sci. 2015, 6, 900. [Google Scholar] [CrossRef]
- Ali, S.; Ganai, B.A.; Kamili, A.N.; Bhat, A.A.; Mir, Z.A.; Bhat, J.A.; Tyagi, A.; Islam, S.T.; Mushtaq, M.; Yadav, P.; et al. Pathogenesis-related proteins and peptides as promising tools for engineering plants with multiple stress tolerance. Microbiol. Res. 2018, 212–213, 29–37. [Google Scholar] [CrossRef]
- Silva, M.S.; Arraes, F.; Campos, M.A.; Grossi-de-Sa, M.; Fernandez, D.; Candido, E.S.; Cardoso, M.H.; Franco, O.L.; Grossi-de-Sa, M.F. Review: Potential biotechnological assets related to plant immunity modulation applicable in engineering disease-resistant crops. Plant Sci. 2018, 270, 72–84. [Google Scholar] [CrossRef]
- Das, K.; Datta, K.; Karmakar, S.; Datta, S.K. Antimicrobial peptides-small but mighty weapons for plants to fight phytopathogens. Protein Pept. Lett. 2019, 26, 720–742. [Google Scholar] [CrossRef] [PubMed]
- Rogozhin, E.A.; Oshchepkova, Y.I.; Odintsova, T.I.; Khadeeva, N.V.; Veshkurova, O.N.; Egorov, T.A.; Grishin, E.V.; Salikhov, S.I. Novel antifungal defensins from Nigella sativa L. seeds. Plant Physiol. Biochem. 2011, 49, 131–137. [Google Scholar] [CrossRef] [PubMed]
- Zhu, X.; Zhao, J.; Abbas, H.; Liu, Y.; Cheng, M.; Huang, J.; Cheng, W.; Wang, B.; Bai, C.; Wang, G.; et al. Pyramiding of nine transgenes in maize generates high-level resistance against necrotrophic maize pathogens. Theor. Appl. Genet. 2018, 131, 2145–2156. [Google Scholar] [CrossRef] [PubMed]
- Liu, B.; Lu, Y.; Xin, Z.; Zhang, Z. Identification and antifungal assay of a wheat β-1,3-glucanase. Biotechnol. Lett. 2009, 31, 1005–1010. [Google Scholar] [CrossRef] [PubMed]
- Wang, K.; Liu, H.; Du, L.; Ye, X. Generation of marker-free transgenic hexaploid wheat via an Agrobacterium-mediated co-transformation strategy in commercial Chinese wheat varieties. Plant Biotechnol. J. 2017, 15, 614–623. [Google Scholar] [CrossRef] [PubMed]
- Saghai-Maroof, M.A.; Soliman, K.M.; Jorgensen, R.A.; Allard, R.W. Ribosomal DNA spacer-length polymorphisms in barley: Mendelian inheritance, chromosomal location, and population dynamics. Proc. Natl. Acad. Sci. USA 1984, 81, 8014–8018. [Google Scholar] [CrossRef]
- Livak, K.J.; Schmittgen, T.D. Analysis of relative gene expression data using real-time quantitative PCR and the 2−ΔΔCt method. Methods 2001, 25, 402–408. [Google Scholar] [CrossRef]
- Zhu, X.; Yang, K.; Wei, X.; Zhang, Q.; Rong, W.; Du, L.; Ye, X.; Qi, L.; Zhang, Z. The wheat AGC kinase TaAGC1 is a positive contributor to host resistance to the necrotrophic pathogen Rhizoctonia cerealis. J. Exp. Bot. 2015, 66, 6591–6603. [Google Scholar] [CrossRef]
- Dong, N.; Liu, X.; Lu, Y.; Du, L.; Xu, H.; Liu, H.; Xin, Z.; Zhang, Z. Overexpression of TaPIEP1, a pathogen-induced ERF gene of wheat, confers host-enhanced resistance to fungal pathogen Bipolaris sorokiniana. Funct. Integr. Genom. 2010, 10, 215–226. [Google Scholar] [CrossRef]

| Lines | T1 | T2 | ||
|---|---|---|---|---|
| IT | DI | IT | DI | |
| DA1 | 2.17 ** | 43.41 ** | 2.50 ** | 50.00 ** |
| DA2 | 1.81 ** | 36.27 ** | 2.57 ** | 51.40 ** |
| DA3 | 2.22 * | 44.36 * | 2.72 * | 54.40 * |
| DA4 | 1.72 ** | 34.47 ** | 2.30 ** | 46.00 ** |
| DA5 | 1.37 * | 27.31 * | 2.68 * | 53.60 * |
| WT | 2.91 | 58.22 | 3.12 | 62.48 |
| Lines | IT | DI |
|---|---|---|
| DA1 | 1.44 ** | 28.80 ** |
| DA2 | 1.23 ** | 24.60 ** |
| DA3 | 1.38 ** | 27.60 ** |
| DA4 | 1.48 ** | 29.60 ** |
| DA5 | 1.33 ** | 26.60 ** |
| WT | 2.27 | 45.40 |
© 2020 by the authors. Licensee MDPI, Basel, Switzerland. This article is an open access article distributed under the terms and conditions of the Creative Commons Attribution (CC BY) license (http://creativecommons.org/licenses/by/4.0/).
Share and Cite
Su, Q.; Wang, K.; Zhang, Z. Ecotopic Expression of the Antimicrobial Peptide DmAMP1W Improves Resistance of Transgenic Wheat to Two Diseases: Sharp Eyespot and Common Root Rot. Int. J. Mol. Sci. 2020, 21, 647. https://doi.org/10.3390/ijms21020647
Su Q, Wang K, Zhang Z. Ecotopic Expression of the Antimicrobial Peptide DmAMP1W Improves Resistance of Transgenic Wheat to Two Diseases: Sharp Eyespot and Common Root Rot. International Journal of Molecular Sciences. 2020; 21(2):647. https://doi.org/10.3390/ijms21020647
Chicago/Turabian StyleSu, Qiang, Ke Wang, and Zengyan Zhang. 2020. "Ecotopic Expression of the Antimicrobial Peptide DmAMP1W Improves Resistance of Transgenic Wheat to Two Diseases: Sharp Eyespot and Common Root Rot" International Journal of Molecular Sciences 21, no. 2: 647. https://doi.org/10.3390/ijms21020647
APA StyleSu, Q., Wang, K., & Zhang, Z. (2020). Ecotopic Expression of the Antimicrobial Peptide DmAMP1W Improves Resistance of Transgenic Wheat to Two Diseases: Sharp Eyespot and Common Root Rot. International Journal of Molecular Sciences, 21(2), 647. https://doi.org/10.3390/ijms21020647

